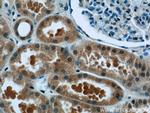
TCTN1 Antibody in Immunohistochemistry (Paraffin) (IHC (P))

Search
Proteintech
TCTN1 Polyclonal Antibody
{{$productOrderCtrl.translations['antibody.pdp.commerceCard.promotion.promotions']}}
{{$productOrderCtrl.translations['antibody.pdp.commerceCard.promotion.viewpromo']}}
{{$productOrderCtrl.translations['antibody.pdp.commerceCard.promotion.promocode']}}: {{promo.promoCode}} {{promo.promoTitle}} {{promo.promoDescription}}. {{$productOrderCtrl.translations['antibody.pdp.commerceCard.promotion.learnmore']}}
产品信息
15004-1-AP
种属反应
已发表种属
宿主/亚型
分类
类型
抗原
偶联物
形式
浓度
规格
纯化类型
保存液
内含物
保存条件
运输条件
产品详细信息
Immunogen sequence: FLVNQAVKC TRKINLEQCE EIEALSMAFY SSPEILRVPD SRKKVPITVQ SIVIQSLNKT LTRREDTDVL QPTLVNAGHF SLCVNVVLEV KYSLTYTDAG EVTKADLSFV LGTVSSVVVP LQQKFEIHFL QENTQPVPLS GNPGYVVGLP LAAGFQPHKG SGIIQTTNRY GQLTILHSTT EQDCLALEGV RTPVLFGYTM QSGCKLRLTG ALPCQLVAQK VKSLLWGQGF PDYVAPFGNS QAQDMLDWVP IHFITQSFNR KDSCQLPGAL VIEVKWTKYG SLLNPQAKIV NVTANLISSS FPEANSGNER TILISTAVTF VDVSAPAEAG FRAPPAINAR LPFNFFFPFV (239-587 aa encoded by BC062611)
靶标信息
TCTN1 is the founding member of the Tectonic protein family, a group of evolutionarily conserved secreted and transmembrane proteins that regulate the Hedgehog (Hh)-mediated patterning of the neural tube. During embryonic development, TCTN1 is expressed in regions that participate in Hh signaling, beginning in the gastrulation stages in the ventral node. Mice expressing mutant TCTN1 die between E13. 5 and E16. 5 and display holoprosencephaly, a defect associated with reduced Hh signaling, indicating the role of TCTN1 as an Hh activator. At later stages in development, TCTN1 is thought to also act as a repressor on the Hh pathway in the anterior and posterior neural tube.
仅用于科研。不用于诊断过程。未经明确授权不得转售。
生物信息学
蛋白别名: extracytosolic protein; Tectonic-1; unnamed protein product
基因别名: G730031O11Rik; JBTS13; RGD1566266; TCTN1; TECT1; UNQ9369/PRO34160
UniProt ID: (Human) Q2MV58, (Mouse) Q8BZ64
Entrez Gene ID: (Human) 79600, (Mouse) 654470, (Rat) 304486